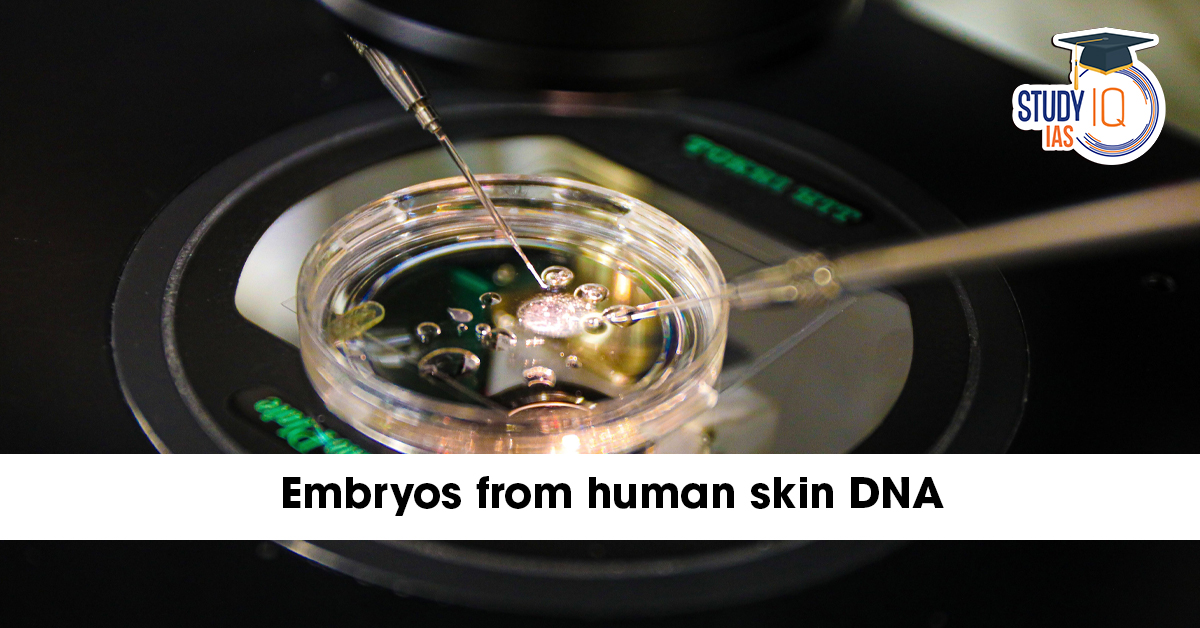

Table of Contents
In a revolutionary scientific breakthrough, researchers in the United States have successfully created embryos from human skin DNA for the first time. This remarkable achievement, which involves turning ordinary skin cells into egg-like cells capable of fertilization, could transform the future of reproductive medicine and infertility treatments.
The research offers hope for millions of individuals who are unable to conceive naturally, including women without viable eggs, men without functional sperm, and people with developmental or genetic reproductive disorders.
What Happened?
US scientists announced that they had managed to create early-stage human embryos from skin DNA, marking a historic step toward what’s known as In Vitro Gametogenesis (IVG) — a technique that could one day allow people to have biological children without the need for traditional sperm and egg cells.
While the embryos are not intended for implantation or development into a fetus, this scientific advancement demonstrates the feasibility of creating gametes (eggs and sperm) entirely in a laboratory setting.
More in News
The experiment’s success paves the way for groundbreaking fertility treatments and genetic studies. According to the researchers, the process could be especially beneficial for:
-
Women who no longer produce viable eggs (due to age or medical conditions).
-
Men with no functional sperm (due to injury or genetic disorders).
-
Individuals with congenital reproductive abnormalities that prevent natural gamete formation.
Moreover, this technique could help same-sex couples or even individuals without partners to produce biologically related offspring, provided ethical and legal frameworks evolve to accommodate such possibilities.
About the Research
Technique Used: In Vitro Gametogenesis (IVG)
In Vitro Gametogenesis (IVG) refers to the process of creating functional gametes (sperm or eggs) from a person’s somatic or stem cells in a laboratory environment.
Through IVG, scientists can reprogram ordinary cells — such as skin cells — into reproductive cells. This offers a new pathway for individuals suffering from irreversible infertility to have their own biological children.
The potential of IVG is immense, but it also raises profound ethical, legal, and moral questions, particularly about cloning, genetic manipulation, and embryo rights.
The Scientific Method: How Researchers Created Embryos from Skin DNA
Step 1: Somatic Cell Nuclear Transfer (SCNT)
Researchers used a method known as Somatic Cell Nuclear Transfer (SCNT) — the same technique used to clone Dolly the sheep in 1996.
In SCNT:
-
The nucleus of a skin cell, which contains the full DNA of an individual, is transferred into a donor egg cell that has had its own nucleus removed.
-
The resulting cell now contains the patient’s genetic material within the structure of an egg.
This reprogrammed egg acts like a natural egg cell, ready for the next stage of fertilization.
Step 2: Mimicking Natural Meiosis through “Mitomeiosis”
One of the biggest challenges in this research was ensuring that the reprogrammed egg had the correct number of chromosomes (23 instead of 46).
To achieve this, scientists developed an innovative process called “Mitomeiosis.”
This process mimics the natural process of meiosis, which normally occurs in the formation of gametes, to remove one set of chromosomes from the reprogrammed cell.
As a result, the egg-like cell had the haploid number (23 chromosomes) required for successful fertilization.
Step 3: Formation of Embryos
Once the reprogrammed egg-like cell with 23 chromosomes was ready, it was fertilized with sperm in vitro, leading to the formation of an early-stage embryo — a human embryo entirely derived from skin cell DNA.
This marks the first time scientists have achieved this milestone using human cells, building upon earlier successes in mice and primates.
Significance of the Discovery
1. Hope for Infertile Individuals
The technique could help individuals with irreversible infertility to have biologically related children — a possibility once thought impossible.
2. Advancement in Genetic Research
It opens new doors for studying genetic diseases, embryonic development, and hereditary disorders, allowing scientists to understand how certain mutations affect fertility or embryogenesis.
3. LGBTQ+ and Single-Parent Reproduction
Theoretically, IVG could allow same-sex couples or even a single person to produce offspring that share their DNA — a possibility that could redefine the concept of family in future generations.
Ethical and Legal Concerns
While the research represents a scientific milestone, it also triggers ethical debates surrounding human cloning and artificial reproduction.
Key concerns include:
-
Creation and destruction of embryos for research purposes.
-
Potential for cloning or designer babies if misused.
-
Regulation and oversight of human embryo research and gene-editing technologies.
Bioethicists emphasize the need for clear international guidelines before such techniques are ever applied clinically.
Global Reaction
The scientific community has welcomed the discovery with both excitement and caution.
While many researchers recognize its potential to revolutionize fertility treatments, they also warn that human applications are still years or even decades away due to ethical, safety, and regulatory hurdles.
Future Prospects
If refined and approved for safe use, this breakthrough could:
-
Eliminate the need for egg or sperm donors in IVF treatments.
-
Help preserve fertility for people undergoing chemotherapy or gender reassignment surgery.
-
Aid in genetic therapy and regenerative medicine by offering deeper insight into how human cells develop and differentiate.
However, extensive testing, ethical review, and long-term safety studies are required before clinical application.
Conclusion
The creation of embryos from human skin DNA marks one of the most extraordinary achievements in modern biotechnology. Using In Vitro Gametogenesis (IVG) and Somatic Cell Nuclear Transfer (SCNT), scientists have taken a crucial step toward redefining the boundaries of fertility science.
This pioneering work could one day enable individuals who are infertile, same-sex couples, or those without gametes to have biologically related children — reshaping the future of human reproduction.
However, as with all scientific breakthroughs, the world must proceed cautiously and ethically, ensuring that innovation aligns with humanity’s moral and social values.

Operation Amistad: India's Humanitarian ...
Operation Amistad: India's Humanitarian ...
 World MSME Day 2026: Theme, History, Sig...
World MSME Day 2026: Theme, History, Sig...
 What is a Seismic Doublet? Venezuela's R...
What is a Seismic Doublet? Venezuela's R...























